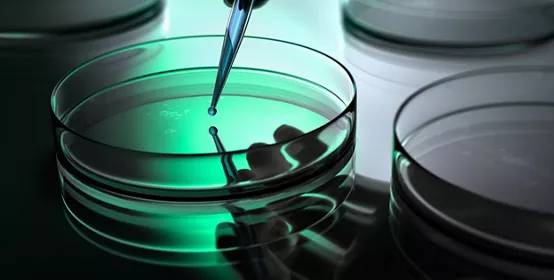
Petri dish full of green fluid - scientific background

常见问题解答:减少气泡、敷形涂料
常见问题解答:减少气泡、敷形涂料
应用指南:
- 材料施工时,尽量缩短原材料和工件的距离,减少气体进入。
- 缩短材料输送行程,降低点胶或喷涂时的压力
- 停止施工作业时,释放机器设备的压力。
- 在气压和材料之间使用压力塞或其他阻隔板(如塞子或顶板),可以有效减少气泡的产生。
如果要通过加热来提高固化速度,在进入烘箱之前要先让溶剂挥发。
对于施工厚度为 3 密耳(75 微米)涂料(如,DOWSIL™ 3-1953 敷形涂料和其他室温固化的 DOWSIL™ 敷形涂料),典型的固化程序是在室温下固化 10 分钟,然后在 60°C 下再固化 10 分钟。
如果敷形涂料起泡,应当在室温下固化更长时间以便使溶剂挥发干净,之后再进烘箱固化。
陶氏电子保护装配学院 - 实验室系列 -真空除气
本视频描述了缓解有机硅产品气泡和空隙形成的方法。本文描述了真空除气过程及其对除气过程的益处。
最常见的污染是“不清洁”或传统的通量残留物。

敷形涂料选择指南
敷形涂料灵活选择。
凝胶、封装胶和敷形涂料
通过最小化应力,最大限度地提高电子部件的可靠性。
我们致力于将您与专家和资源连接起来以应对任何挑战。
